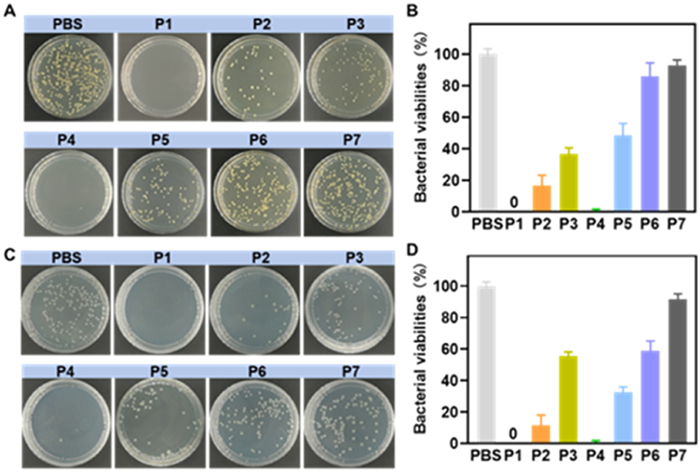

-
[1]
M.F. Moradali, B.H.A. Rehm, Nat. Rev. Microbiol. 18 (2020) 195–210.
doi: 10.1038/s41579-019-0313-3
-
[2]
D.G.J. Larsson, C.F. Flach, Nat. Rev. Microbiol. 20 (2021) 257–269.
-
[3]
M.T.Q. Duong, Y.S. Qin, S.H. You, J.J. Min, Exp. Mol. Med. 51 (2019) 1–15.
doi: 10.1038/s12276-019-0297-0
-
[4]
A.Q. Zeng, R.J. Yang, Y.J. Tong, W. Zhao, Int. J. Biol. Macromol. 235 (2023) 123749.
-
[5]
Y. Xue, L. Zhang, J.H. Zhou, et al., Adv. Funct. Mater. 34 (2023) 2308197.
-
[6]
Z. Li, E.G. Wang, Y.Z. Zhang, et al., Nano Today 50 (2023) 101826.
doi: 10.1016/j.nantod.2023.101826
-
[7]
H.L. Zhang, Y.B. Gao, J.G. Gai, et al., J. Mater. Chem. A 6 (2018) 6442–6454.
doi: 10.1039/c8ta00342d
-
[8]
Z.L. Li, J. Chen, W. Cao, et al., Carbohydr. Polym. 180 (2018) 192–199.
doi: 10.3747/pdi.2017.00222
-
[9]
Y.X. Zheng, N.Y. Pan, Y. Liu, X.H. Ren, Carbohydr. Polym. 253 (2021) 117205.
doi: 10.1016/j.carbpol.2020.117205
-
[10]
H. Wen, Q.H. Wu, L.Q. Liu, et al., Biomater. Sci. 11 (2023) 2870–2876.
doi: 10.1039/d3bm00073g
-
[11]
X.W. Fu, Z.Y. Yang, T. Deng, et al., J. Mater. Chem. B 8 (2020) 1481–1488.
doi: 10.1039/c9tb02482d
-
[12]
W. Shen, P. He, C.S. Xiao, X.S. Chen, Adv. Healthc. Mater. 7 (2018) 1800354.
doi: 10.1002/adhm.201800354
-
[13]
L. Rojo, L.G. Fernández, M.R. Aguilar, B.V. Lasa, Curr. Opin. Biotechnol. 76 (2022) 102752.
doi: 10.1016/j.copbio.2022.102752
-
[14]
M.E. Schafer, H. Browne, J.B. Goldberg, D.E. Greenberg, Acc. Chem. Res. 54 (2021) 2377–2385.
doi: 10.1021/acs.accounts.1c00040
-
[15]
M. Yi, T.D. Nguyen, H. Liu, et al., Adv. Funct. Mater. 33 (2023) 2213471.
doi: 10.1002/adfm.202213471
-
[16]
C.M. Nuñez, R.C. Rodríguez, C. Echeverría, M.F. García, A.M. Bonilla, Carbohydr. Polym. 302 (2023) 120438.
doi: 10.1016/j.carbpol.2022.120438
-
[17]
C.C. Hanna, Y.O. Hermant, P.W.R. Harris, M.A. Brimble, Acc. Chem. Res. 54 (2021) 1878–1890.
doi: 10.1021/acs.accounts.0c00841
-
[18]
D. Ciumac, H.N. Gong, X.Z. Hu, J.R. Lu, J. Colloid. Interface Sci. 537 (2019) 163–185.
doi: 10.1016/j.jcis.2018.10.103
-
[19]
Y.M. Wu, K. Chen, J.Z. Wang, et al., Prog. Polym. Sci. 141 (2023) 101679.
doi: 10.1016/j.progpolymsci.2023.101679
-
[20]
Y.M. Qian, H.Q. Cui, R.W. Shi, et al., Eur. Polym. J. 107 (2018) 181–188.
doi: 10.1016/j.eurpolymj.2018.07.044
-
[21]
Y. Liu, Y.F. Li, D. Keskin, L.Q. Shi, Adv. Healthc. Mater. 8 (2018) 1801359.
-
[22]
W.P. Xu, Z. Ma, G. Dhanda, J. Haldar, H.X. Xie, Chin. Chem. Lett. 34 (2023) 107847.
doi: 10.1016/j.cclet.2022.107847
-
[23]
C.F. Yang, Z.L. Xue, Y.L. Liu, et al., Mater. Sci. Eng. C 84 (2018) 254–262.
doi: 10.1016/j.msec.2017.12.003
-
[24]
H. Sun, C.P. Kabb, Y.Q. Dai, et al., Nat. Chem. 9 (2017) 817–823.
doi: 10.1038/nchem.2730
-
[25]
F. Qi, Y.X. Qian, N. Shao, et al., ACS Appl. Mater. Interfaces 11 (2019) 18907–18913.
doi: 10.1021/acsami.9b02915
-
[26]
J. Yan, L.C. Zheng, K. Hu, et al., Eur. Polym. J. 110 (2019) 41–48.
doi: 10.1016/j.eurpolymj.2018.11.009
-
[27]
A.L. Lakes, R. Peyyala, J.L. Ebersole, et al., Biomacromolecules 15 (2014) 3009–3018.
doi: 10.1021/bm5006323
-
[28]
Z.C. Guo, W.W. Liu, T.F. Liu, et al., Chin. Chem. Lett. 35 (2023) 109060.
-
[29]
J. Kim, H. Yu, E. Yang, Y. Choi, P.S. Chang, LWT 174 (2023) 114421.
doi: 10.1016/j.lwt.2022.114421
-
[30]
J. Qin, J.N. Guo, Q.M. Xu, et al., ACS Appl. Mater. Interfaces 9 (2017) 10504–10511.
doi: 10.1021/acsami.7b00387
-
[31]
M. Zeng, D.Z. Zhou, F. Alshehri, et al., Nano Lett. 19 (2018) 381–391.

 Login In
Login In







 DownLoad:
DownLoad: